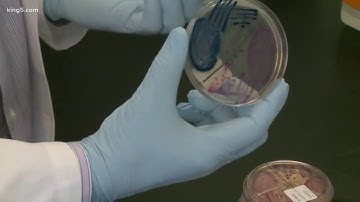
Experts warn of "superbug" threat

⬇ DOWNLOAD NOW
Kalau muncul iklan pop-up, tutup lalu klik tombol kembali
Download lagu Warning over superbug threat secara gratis hanya untuk keperluan promosi. Dukung artis favorit kamu dengan membeli musik original di iTunes atau platform resmi lainnya.
 Superbug warning to drug giants
Superbug warning to drug giants
 Antibiotics and the Emerging Superbug Threat
Antibiotics and the Emerging Superbug Threat
 “CDC Warning: Superbugs on the Rise — Protect Yourself Naturally”
“CDC Warning: Superbugs on the Rise — Protect Yourself Naturally”
 The Global Health Crisis No One Is Fighting: Superbug Threat
The Global Health Crisis No One Is Fighting: Superbug Threat
 Superbug Alert: Understanding the Threat of VRE
Superbug Alert: Understanding the Threat of VRE
 Superbug threat requires urgent action
Superbug threat requires urgent action
 Superbug threat still lurking on surfaces
Superbug threat still lurking on surfaces
Experts warn of "superbug" threat
Experts warn of "superbug" threat